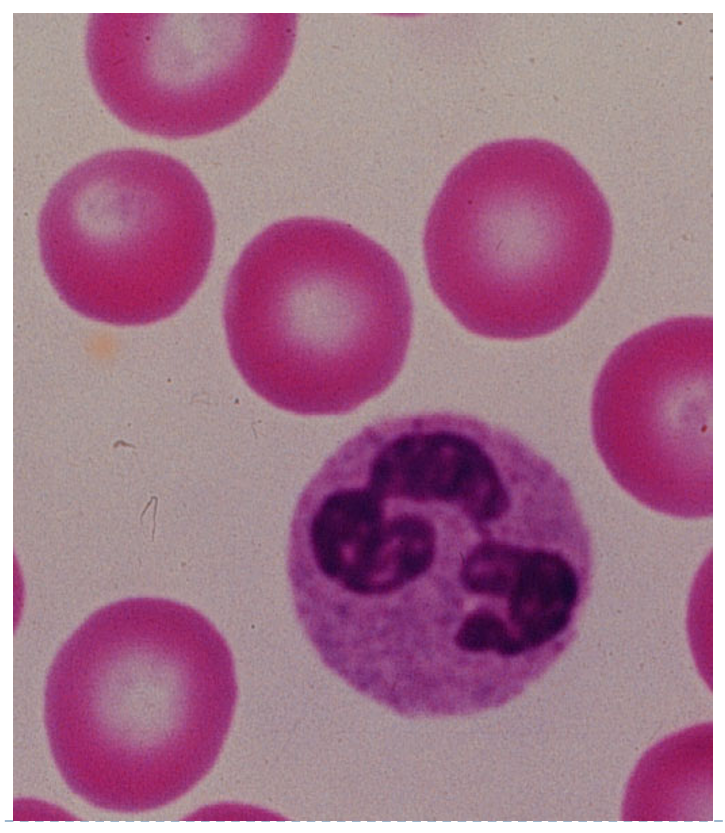

What is acute inflammation ?
The immediate and early response to injury, designed to deliver leukocytes to the site of injury
Can be beneficial but also harmful
What are the two types of inflammation ?
Acute
-Initial and often transient series of tissue reactions to injury
Chronic
-Subsequent and often prolonged tissue response following initial acute response
What are causes of inflammation ?
Microbial infections
-E.g. bacteria & viruses
Hypersensitivity reactions
-Excessive immune response leading to tissue damage
Physical agents
-Trauma, radiation or heat injury
Chemicals
-Corrosives, acids or bacterial toxins
Tissue necrosis
-e.g. secondary to ischaemia
-lots of acute inflammatory infiltrate seen in necrotic tissue
virtually identical to causes of injury
How can microbrial infections stimulate inflammation ?
Bacterial
-Exotoxins; chemicals released by bacteria
-Endotoxins; associated with bacterial cells walls
Virus
-Intracellular multiplication; leads to cell death, debris stimualtes inflammation
Organisms can also cause hypersensitivity reactions
e.g. some parasitic infections and TB

What is hypersensitivity ?
Excess immune response due to altered state of immunological responsiveness
How do Physical Agents and Chemicals cause inflammation ?
Cause tissue damage (see previous lecture)
Presence of damaged/dead tissue provokes inflammatory response
How does tissue necrosis cause inflammation ?
Dead tissue releases peptides
Triggers acute inflammatory response
What are the cardinal signs of inflammation ?
Redness (rubor)
-Bc vessel dilation
Heat (calor)
-Bc increase blood flow
Swelling (tumor)
-Bc accumulation of fluid and increase in inflammatory cells migrating to the area
Pain (dolor)
-Bc physical distortion of tissue and due to release of some chemical mediators (prostaglandins, bradykinin)
Loss of function of inflammed area (functio laesa)
What are the stages of inflammation
Rough order
1) Release of chemical mediators
2) Vasodilatation
3) Increased vascular permeability (lets cells move through)
4) Fluid accumulation
5) Cellular recruitment
6) Phagocytosis
Neutrophil diapedesis, moves down chemotacctic gradient, phagocytosis

chemotacctic gradient is a chemical gradient
What are the two major components in early inflammation ?
Vascular changes
-Change in vessel calibre
-Increase in vascular permeability
Cellular events
-Formation of cellular exudate
Describe changes in vessel calibre in early inflammation
There is initial transient constriction
-Often as injury response, minimise blood loss
Then vasodilation
-Can last from 15 mins up to several hours
-Gets more neutrophils in
Describe the purpose of increased vascular permeability in early inflammation ?
Allows for increased net flow of fluid out of vessels - “exudation”
-lets fluid into injured tissue, can dilute toxins in injured/poisoned areas

Describe formation of cellular exudate in early inflammation
Involves accumulation of neutrophil polymorphs
-Nuetrophils are characteristic cell of acute inflammatory response
Neutrophils move out of vessel into tissue by diapedesis
Why are neutrophils so amazing?
Motile
-Move by calcium depedent cytoplasmic microtubule contraction or chemotaxis
-By contracting cytoplasmic microtubules; dependent on calcium ions
-e.g. chemotaxis in response to inflammatory chemicals
Can stick to opsonised microbes
-Once bacteria have encountered immunoglobulins or complement components, neutrophils can bind to them
Phagocytosis
-Can gobble up particles e.g. cellular debris
-Can gobble up microbes and kill them
-Variety of intracellular methods to produce microbicidal agents E.g. producing hydrogen peroxidase, to react with cytoplasmic myeloperoxidase
How do neutrophils move into damaged/infected tissues?
Margination
-Loss of intravascular fluid which slows flow to site allows them to sow down and move to side of vessel
Adhesion (aka pavementing)
-Neutrophils adhere to vascular endothelium
-Caused by interaction between paired adhesion molecules on the neutrophil and endothelial surfaces
Emigration
-Pass between endothelial cells, through basal lamina and into adventitia and tissue
Adventita in capillaries here means surrounding tissue and mass

What are the components of the inflammatory response ?
Cells and chemical agents
What are the cellular components of the inflammtory response ?
Endothelial and inflammatory cells (e.g. naeutrophils)
What are the chemical agents component of the inflammtory response ?
Cytokines
Complement
Histamine
Prostaglandins
Lysosomal Compounds
Leukotrienes
Seratonin
Chemokines
Plasma factors
Describe the role of chemical mediators in early chemical events
Histamine and thromin released by original inflammatory stimulus
-Cause up regulation of P-selectin and platelet activating factor (PAF) onendothelial cells
Neutrophils start to roll along endothelial wall
-Ligands on the neutrophil surface engage with the P-selectin onendothelial cells
PAF docks with corresponding receptor on neutrophil and promotes expression of other molecules (LFA-1, MAC-1)
-overall end result is firm neutrophil adhesion to endothelial surface
What is histamine ?
Is a chemical mediator released from a cell
-Causes vascular dilation and permeability
-Released mainly by mast cells (an immune cell that lives in connective tissue, waiting to be activated)
-Also plays a role in neutrophil adhesion to endothelium

What are Lysosomal compounds ?
Chemical mediator of acute inflammatory response
-Lots of different functions, such as vascular permeability
-Some can stimulate histamine release from mast cells
-Released by neutrophils
What are leukotrienes ?
Chemical mediator of acute inflammatory response
-Vasoactive properties
-Often made in neutrophils from arachidonic acid
What are prostoglandins ?
Chemical mediator of acute inflammatory response
-Derived from arachidonic acid
-Some cause increased vacular permeability
-Some cause platelet aggregation
-Released by lots of cell types
What is seratonin ?
Chemical mediator of acute inflammatory response
-Vasoconstrictor
-Released by platelets
-Immediate after injury


